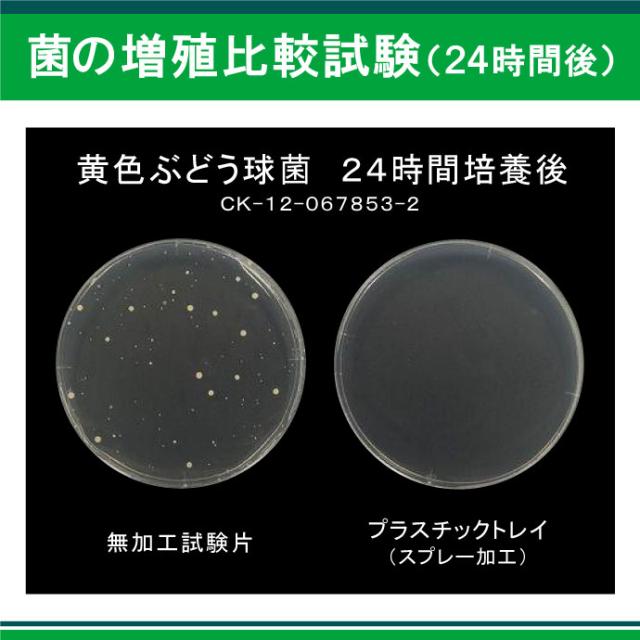

94%がすすめる マスクスプレー 30ml 消臭 除菌 NANOプラチナ 花粉 対策 無香料 ミスト 防カビ 抗菌 長時間除菌 送料無料
(28件)
1,580円(税込)
0ポイント(1%)
商品説明
【使用方法】:
マスク、衣類、寝具、カーテン、ペット用品等やお部屋のニオイや菌が気になるところに。
・マスク全体にスプレーし1日2〜3回以上のスプレーをおすすめします。
・マスクの両面にスプレーすると事でさらに効果は高まります。
・マスクなどにスプレーした場合は乾いた後にご使用願います(湿った状態でご使用しても刺激はございません)
※現在容器が不足してるためサイズ・デザインが異なる事があります。ご了承願います。
【特許プラチナシールド技術活用!】特許技術の特徴
1・繰り返し使用できるマスク スプレー 長時間除菌!
2・マスク、衣料品などの消臭・防カビ!
3・空気清浄器・加湿器のミストにより、お部屋全体に広がり布団・枕・カーテン・壁紙・タンス・花瓶、衣料品、テーブルやイス等の除菌・消臭・防カビを可能に!
【驚異的な除菌力】
4・タンクの水 180日,半年間の長時間除菌テスト合格!
(優しく清潔な水、キレイな水が続く!)
5・タンクの水の防カビ・除菌・消臭を可能に、タンクのヌメリ防止!
6・無香料・無臭・無刺激(安全性試験すべて合格)!
7・防腐剤無添加・ノンアルコール・パラベンフリー・植物性/化学性の除菌剤 防腐剤は一切未使用・安心安全・優しい・弱酸性・非塩素!
【非次亜塩素酸・非カルキ】
8・花粉対策やペット臭、生ゴミ・トイレ・お風呂場・タバコ臭などの消臭・除菌・防カビに!
【特許取得・プラチナシールド技術・説明】
長時間除菌を可能にしたプラチナシールド固定化技術により、塩素やアルコールを使用せず、刺激性が無く優しいNANOプラチナの驚異的な除菌力で長時間の除菌・消臭効果を可能にしました。
加湿器・空気清浄機のタンクなどの菌・臭いを除去し、優しく刺激性が無く、長時間除菌を可能にしたNANOプラチナは除菌・消臭対策などに適して活用されてます。
【無香料】優しく無刺激で刺激性が無く、食品成分のみを使用した安心安全な素材です。
【備考】:
◆設置場所・使用時間・部屋の大きさ・加湿器等の性能によって効果は異なります。全ての菌・カビ・ニオイに対して効果があるわけではありません。
◆本品にマスクは付いてません。スプレーのみ販売です。写真はイメージです。御了承願います。
◆ご使用の前には、よく振ってからご使用願います。また、中身の除菌剤が変色、容器に着色する事や、沈殿する事がございますが品質に問題はございません。
◆マスクなどにスプレーした場合は乾いた後にご使用願います(湿った状態でご使用しても刺激はございません)
◆お届けについてのお問い合わせは、運送会社営業所へ直接ご連絡願います。
◆配送について・納品日・営業時間の問合せ等は、配送方法(PC)のページに記載されておりますので御了承願います。




























マスク、衣類、寝具、カーテン、ペット用品等やお部屋のニオイや菌が気になるところに。
・マスク全体にスプレーし1日2〜3回以上のスプレーをおすすめします。
・マスクの両面にスプレーすると事でさらに効果は高まります。
・マスクなどにスプレーした場合は乾いた後にご使用願います(湿った状態でご使用しても刺激はございません)
※現在容器が不足してるためサイズ・デザインが異なる事があります。ご了承願います。
【特許プラチナシールド技術活用!】特許技術の特徴
1・繰り返し使用できるマスク スプレー 長時間除菌!
2・マスク、衣料品などの消臭・防カビ!
3・空気清浄器・加湿器のミストにより、お部屋全体に広がり布団・枕・カーテン・壁紙・タンス・花瓶、衣料品、テーブルやイス等の除菌・消臭・防カビを可能に!
【驚異的な除菌力】
4・タンクの水 180日,半年間の長時間除菌テスト合格!
(優しく清潔な水、キレイな水が続く!)
5・タンクの水の防カビ・除菌・消臭を可能に、タンクのヌメリ防止!
6・無香料・無臭・無刺激(安全性試験すべて合格)!
7・防腐剤無添加・ノンアルコール・パラベンフリー・植物性/化学性の除菌剤 防腐剤は一切未使用・安心安全・優しい・弱酸性・非塩素!
【非次亜塩素酸・非カルキ】
8・花粉対策やペット臭、生ゴミ・トイレ・お風呂場・タバコ臭などの消臭・除菌・防カビに!
【特許取得・プラチナシールド技術・説明】
長時間除菌を可能にしたプラチナシールド固定化技術により、塩素やアルコールを使用せず、刺激性が無く優しいNANOプラチナの驚異的な除菌力で長時間の除菌・消臭効果を可能にしました。
加湿器・空気清浄機のタンクなどの菌・臭いを除去し、優しく刺激性が無く、長時間除菌を可能にしたNANOプラチナは除菌・消臭対策などに適して活用されてます。
【無香料】優しく無刺激で刺激性が無く、食品成分のみを使用した安心安全な素材です。
【備考】:
◆設置場所・使用時間・部屋の大きさ・加湿器等の性能によって効果は異なります。全ての菌・カビ・ニオイに対して効果があるわけではありません。
◆本品にマスクは付いてません。スプレーのみ販売です。写真はイメージです。御了承願います。
◆ご使用の前には、よく振ってからご使用願います。また、中身の除菌剤が変色、容器に着色する事や、沈殿する事がございますが品質に問題はございません。
◆マスクなどにスプレーした場合は乾いた後にご使用願います(湿った状態でご使用しても刺激はございません)
◆お届けについてのお問い合わせは、運送会社営業所へ直接ご連絡願います。
◆配送について・納品日・営業時間の問合せ等は、配送方法(PC)のページに記載されておりますので御了承願います。

【NANO プラチナ マスクスプレー!】
【日本製】・繰り返し使用できる マスク スプレー 長時間除菌!
・長時間除菌で防ぐ!抗菌消臭スプレー
・ペット臭・たばこ臭・部屋干し臭・汗臭・車内のニオイ・生活臭対・防カビ対策
【成分】:白金、香料、精製水、その他※無香料には香料は入っていません。【特徴】:非塩素・ノンアルコール・パラベンフリー・【防腐剤無添加】アルコール・塩素は使用してません(無刺激)【安心・安全プラチナ除菌アロマ】
【容量】:30ml【香り】:無香料・ローズ・ネロリ・ラベンダー【生産】:日本製 太陽薬品株式会社
【日本製】・繰り返し使用できる マスク スプレー 長時間除菌!
・長時間除菌で防ぐ!抗菌消臭スプレー
・ペット臭・たばこ臭・部屋干し臭・汗臭・車内のニオイ・生活臭対・防カビ対策
【成分】:白金、香料、精製水、その他※無香料には香料は入っていません。【特徴】:非塩素・ノンアルコール・パラベンフリー・【防腐剤無添加】アルコール・塩素は使用してません(無刺激)【安心・安全プラチナ除菌アロマ】
【容量】:30ml【香り】:無香料・ローズ・ネロリ・ラベンダー【生産】:日本製 太陽薬品株式会社
レビュー
- 除菌効果を期待して〜
- マスク必須のため、購入しました。 1本プレゼントを頂け、香り付きで気分転換ができ嬉しいです?
- 液体漏れ
- 届いて開封したら液体が漏れていた もう買わないと思う
- 目に見えませんので
- 加湿機能付きの空気清浄機に使っていますが 匂いも無く効果があるのかどうか、実感がありませんが、きっと除菌してくれていると信じています。
- 遅くなりました??
- 投稿したものと思って折りました。 申し訳ございません。
- リピ買い☆
- 前回までのは姉にあげちゃったので、自分用に購入☆
すべてのレビューを見る
お店の情報
お店の評価:



-点(0件)
連絡・応対
-
配送スピード
-
梱包
-








